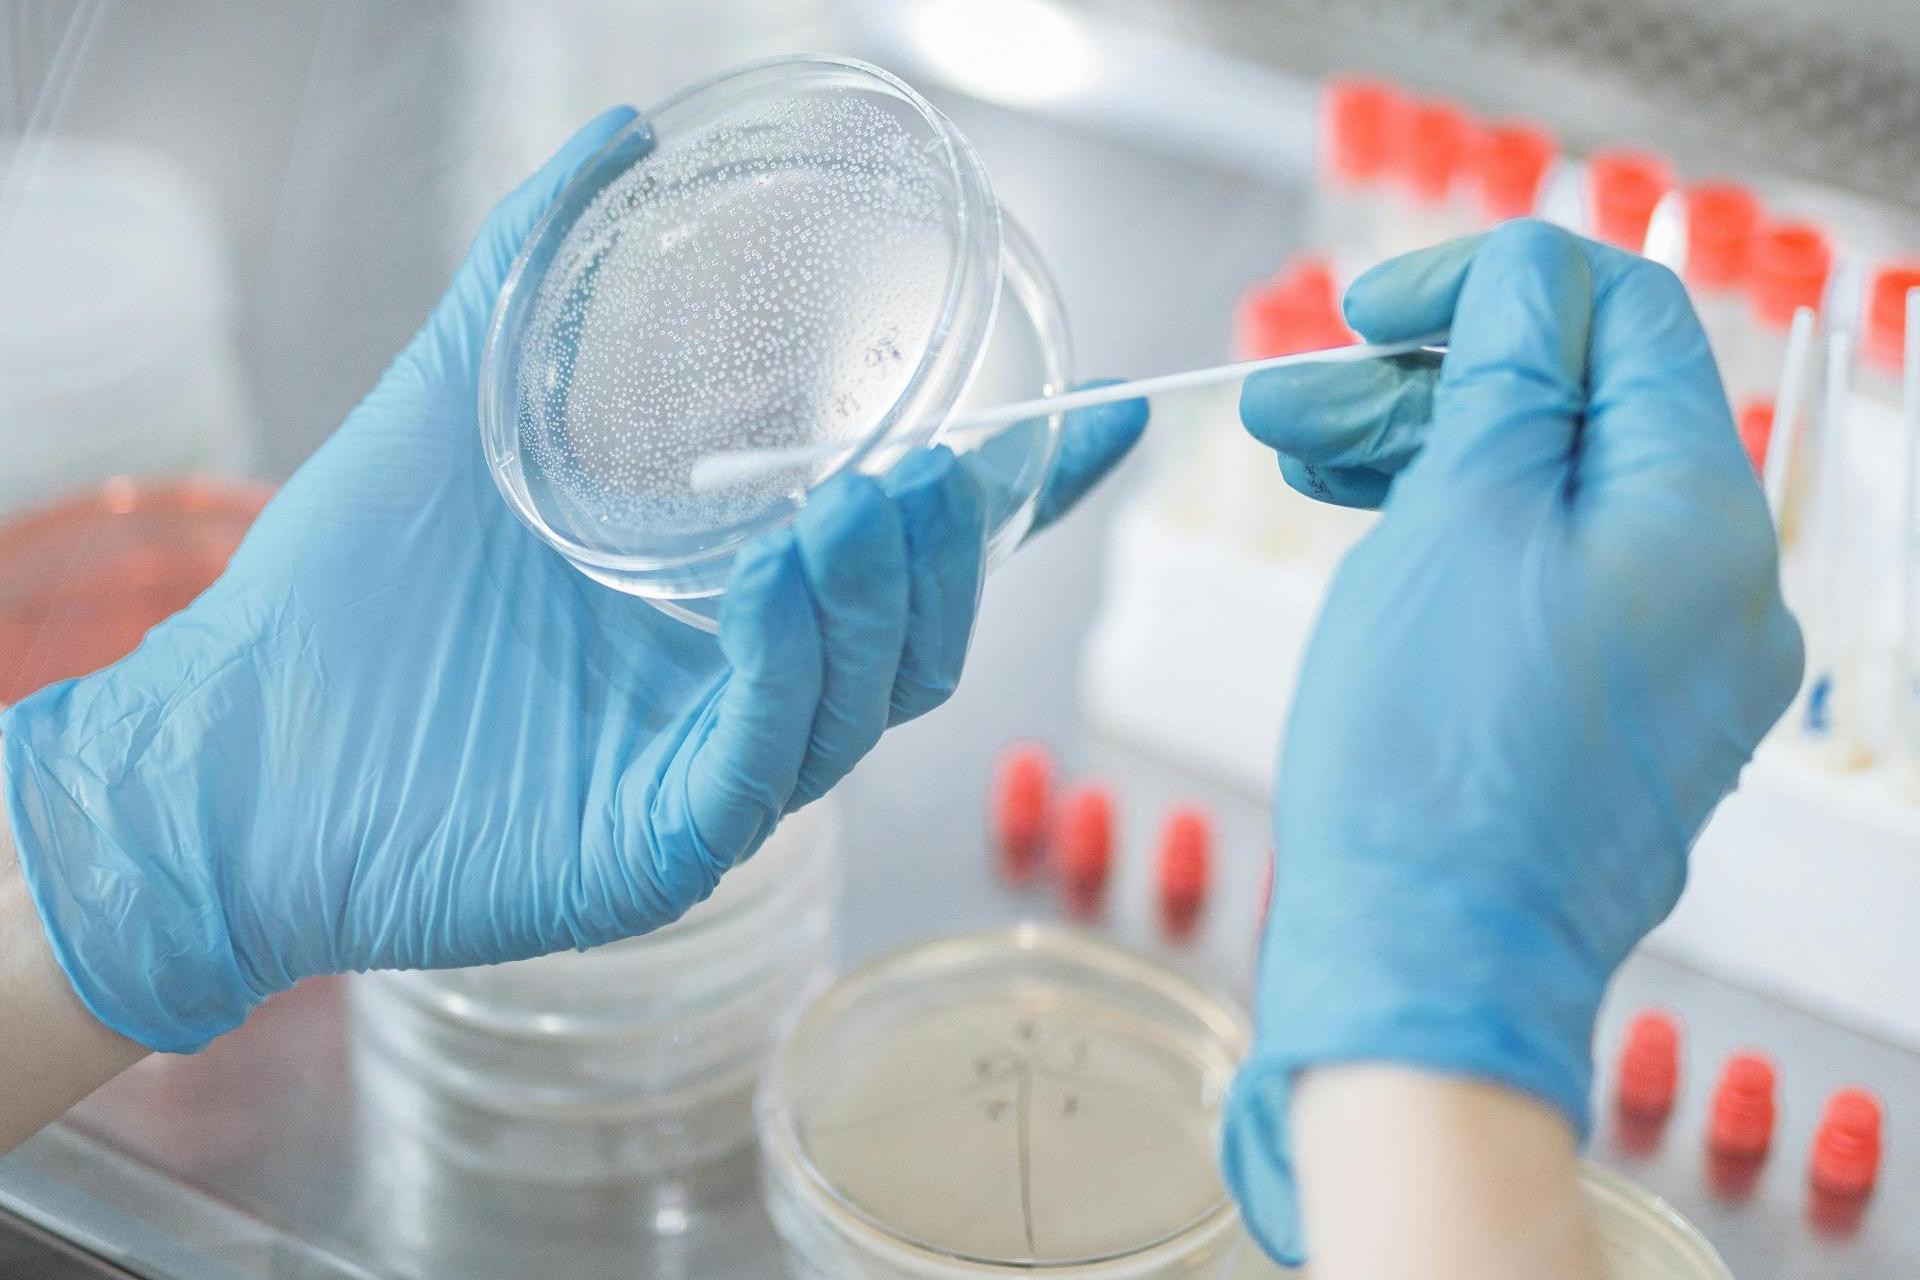

Где берут смывы
Поезд 290 екатеринбург анапа расписание
Что пишут в актах на списание
Планшет galaxy tab s6 lite отзывы
Характеристика микрофинансовых организаций
Ошибки хонда прочитать
Цып цып касатки
Я буду тогда обладать
Пальмира палас резорт и спа
Основные команды клуб
Iphone 15 128 gb black
Загадки для детей 6 7 лет презентация
Активировать карту водителя
Удобрение viva
Где берут смывы 114 фото